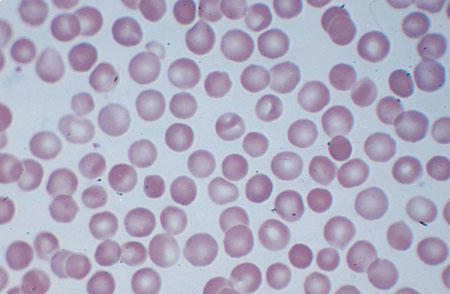
اسفروسیتوزیز . گلبول های هایپرکروماتیک کوچک
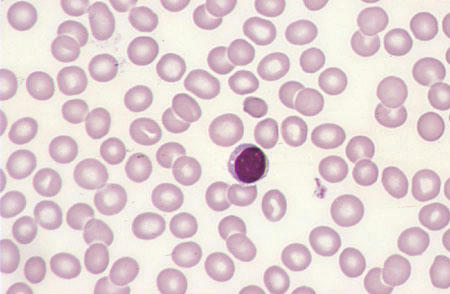
گلبول قرمز نرمال . لنفوسیت کوچک در وسط میدان
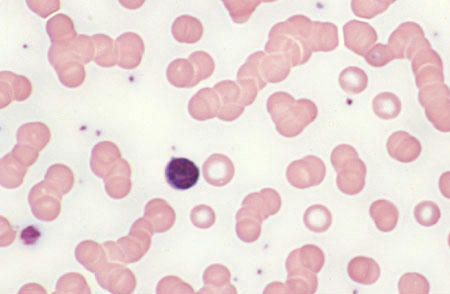
پدیده رولکس (سکه ای خودمون ) . لنفوسیت کوچک در وسط میدان
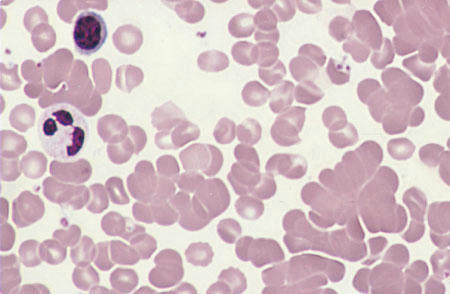
لخته شدن گلبولها . لنفوسیت کوچک و نوتروفیل هایپرسیگمانته در گوشه بالا سمت چپ
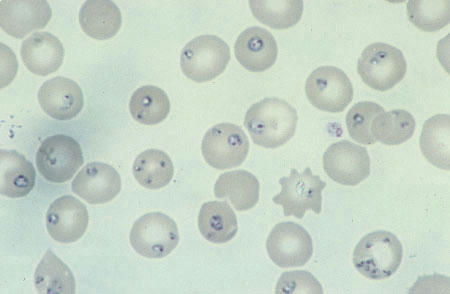
انگل بابزیا در داخل گلبول
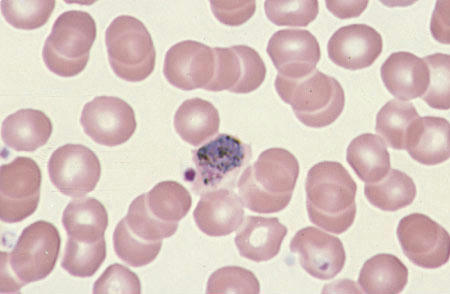
تروفازوئید پلاسمدیوم ویواکس در داخل گلبول

گلبول های قرمز نرمال . لنفوسیت کوچک در وسط میدان
هایپرکروموزیا و میکروسیتیک کم . کم خونی اولیه آهن . لنفوسیت کوچک در گوشه راست میدان

هیپرکرومازیا و میکروسیتیک زیاد . کم خونی اهن . لنفوسیت کوچک در میدان

پلی کروموتوفیلی . گلبول های بزرگ با رنگ بنفش کم رنگ

ماکروسیتوزیز

اسفروسیتوزیز . گلبول های هایپرکروماتیک کوچک
گلبول قرمز نرمال . لنفوسیت کوچک در وسط میدان
پدیده رولکس (سکه ای خودمون ) . لنفوسیت کوچک در وسط میدان
لخته شدن گلبولها . لنفوسیت کوچک و نوتروفیل هایپرسیگمانته در گوشه بالا سمت چپ
انگل بابزیا در داخل گلبول
تروفازوئید پلاسمدیوم ویواکس در داخل گلبول
برچسبها: گلبول قرمز, مورفولوژی گلبول قرمز
+ نوشته شده در جمعه ۱۳۸۸/۰۶/۲۰ساعت 4:35  توسط امیر
|